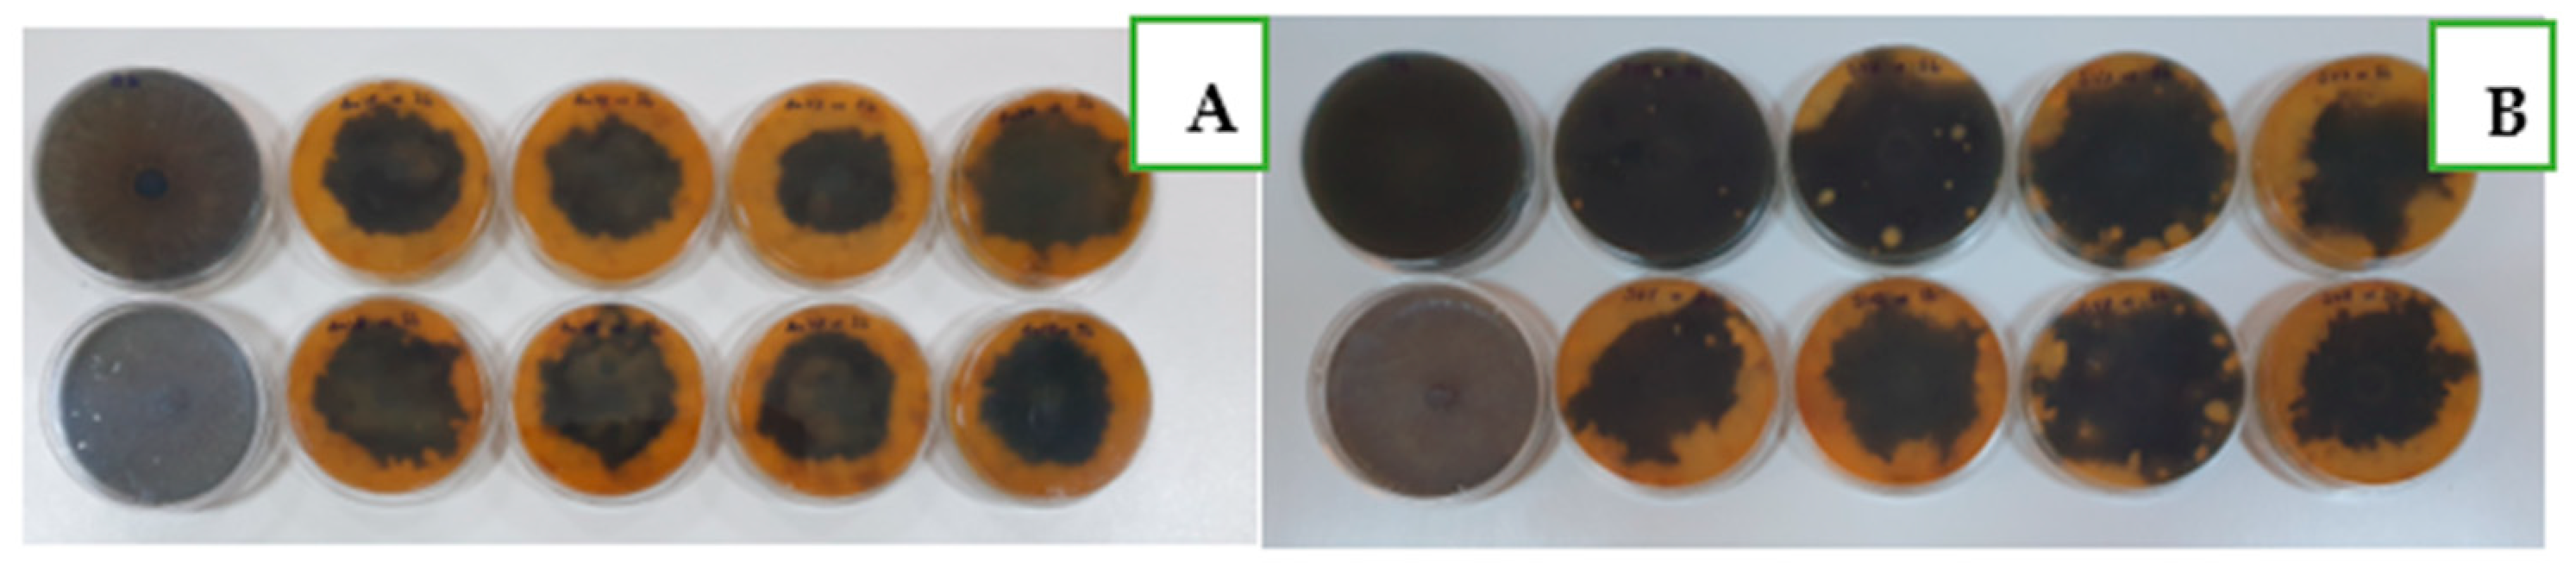
Agronomy 13 02837 g005

Soil Chemical Properties and Microbial Behavior under Short-Term Organic and Mineral Fertilization within Different Crops
Abstract
:1. Introduction
2. Materials and Methods
2.1. Site Description
2.2. Soil Analysis
2.2.1. Soil Physicochemical Characteristics Analysis
2.2.2. Soil Microbiological Characteristics Analysis
2.3. Manure Compost Chemical and Microbiological Characteristics Analysis
2.4. Experimental Design
2.5. Statistical Analysis
- -
- ns: non-significant differences;
- -
- * significant differences between the fertilized variants and the control;
- -
- ** distinct significant differences between the fertilized variants and the control;
- -
- *** very significant differences between the fertilized variants and control.
- -
- o—significant negative differences between the fertilized variant and control;
- -
- oo—distinctly significant negative differences between the fertilized variant and the control;
- -
- ooo—very significant negative differences between the fertilized variant and the control.
3. Results
3.1. Manure Compost Chemical and Microbiological Characteristics
3.2. Variation of Soil Chemical Properties under Organic and Chemical Fertilizer Application and Different Crop Cultivation
3.3. Variation of Soil Microbial Abundance and Their Antifungal Efficiency under Organic and Mineral Fertilization and after Different Crop Cultivation
4. Discussion
5. Conclusions
Supplementary Materials
Author Contributions
Funding
Institutional Review Board Statement
Informed Consent Statement
Data Availability Statement
Acknowledgments
Conflicts of Interest
References
- Breure, A.M.; De Deyn, G.B.; Dominati, E.; Eglin, T.; Hedlund, K.; Van Orshoven, J.; Posthuma, L. Ecosystem services: A useful concept for soil policy-making! Curr. Opin. Environ. Sustain. 2012, 4, 578–585. [Google Scholar] [CrossRef]
- Ferrarini, A.; Bini, C.; Amaducci, S. Soil and ecosystem services: Current knowledge and evidences from Italian case studies. Appl. Soil Ecol. 2018, 123, 693–698. [Google Scholar] [CrossRef]
- Williams, T.G.; Guikema, S.D.; Brown, D.G.; Agrawal, A. Resilience and equity: Quantifying the distributional effects of resilience enhancing strategies in a smallholder agricultural system. Agric. Syst. 2020, 182, 102832. [Google Scholar] [CrossRef]
- Melero, S.; Madejón, E.; Ruiz, J.C.; Herencia, J.F. Chemical and biochemical properties of a clay soil under dryland agriculture system as affected by organic fertilization. Eur. J. Agron. 2007, 26, 327–334. [Google Scholar] [CrossRef]
- Sofo, A.; Zanella, A.; Ponge, J.F. Soil quality and fertility in sustainable agriculture, with a contribution to the biological classification of agricultural soils. Soil Use Manag. 2022, 38, 1085–1112. [Google Scholar] [CrossRef]
- Li, K.; Wang, C.; Zhang, H.; Zhang, J.; Jiang, R.; Feng, G.; Liu, X.; Zuo, Y.; Yuan, H.; Zhang, C.; et al. Evaluating the effects of agricultural inputs on the soil quality of smallholdings using improved indices. Catena 2022, 209, 105838. [Google Scholar] [CrossRef]
- Li, Y.; Zeng, C.; Long, M. Variation of soil nutrients and bacterial community diversity of different land utilization types in Yangtze River Basin, Chongqing Municipality. PeerJ 2020, 8, e9386. [Google Scholar] [CrossRef]
- Nguemezi, C.; Tematio, P.; Yemefack, M.; Tsozue, D.; Silatsa, T.B.F. Soil quality and soil fertility status in major soil groups at the Tombel area, South-West Cameroon. Heliyon 2020, 6, e03432. [Google Scholar] [CrossRef]
- Spínola Garcia Távora, G.; Dias Turetta, A.P.; Soares da Silva, A.; Teixeira Simões, B.F.; Nehren, U. Trade-offs and synergies in agricultural landscapes: A study on soil-related ecosystem services in the Brazilian Atlantic rainforest. Environ. Sustain. Ind. 2022, 16, 100205. [Google Scholar] [CrossRef]
- Gogoi, B.; Borah, N.; Baishya, A.; Nath, D.J.; Dutta, S.; Das, R.; Bhattacharyya, D.; Sharma, K.K.; Valente, D.; Petrosillo, I. Enhancing soil ecosystem services through sustainable integrated nutrient management in double rice-cropping system of North-East India. Ecol. Ind. 2021, 132, 108262. [Google Scholar] [CrossRef]
- Gafencu, A.M.; Florea, A.M.; Ulea, E. Influence of seed-protectant pesticides on soil Azotobacter and Clostridium nitrogen fixing bacteria. Scient. Pap. Ser. A Agron. 2021, LXIV, 92–97. [Google Scholar]
- Rasmussen, P.E.; Albrecht, S.L.; Smiley, R.W. Soil C and N changes under tillage and cropping systems in semi-arid Pacific Northwest agriculture. Soil Till. Res. 1998, 47, 197–205. [Google Scholar] [CrossRef]
- Velthof, G.; Barot, S.; Bloem, J.; Butterbach-Bahl, K.; de Vries, W.; Kros, J.; Lavelle, P.; Eivind Olesen, J.; Oenema, O. Nitrogen as a Threat to European Soil Quality. In The European Nitrogen Assessment: Sources, Effects and Policy Perspectives; Sutton, M., Howard, C., Erisman, J., Billen, G., Bleeker, A., Grennfelt, P., Van Grinsven, H., Grizzetti, B., Eds.; Cambridge University Press: Cambridge, UK, 2011; pp. 495–510. [Google Scholar]
- Celik, I.; Gunal, H.; Budak, M.; Akpinar, C. Effects of long-term organic and mineral fertilizers on bulk density and penetration resistance in semi-arid Mediterranean soil conditions. Geoderma 2010, 160, 236–243. [Google Scholar] [CrossRef]
- Krasilnikov, P.; Taboada, M.A.; Amanullah. Fertilizer use, soil health and agricultural sustainability. Agriculture 2022, 12, 462. [Google Scholar] [CrossRef]
- Zhang, Z.; Yu, Z.; Zhang, Y.; Shi, Y. Impacts of fertilization optimization on soil nitrogen cycling and wheat nitrogen utilization under water-saving irrigation. Front. Plant Sci. 2022, 13, 878424. [Google Scholar] [CrossRef] [PubMed]
- Francioli, D.; Schulz, E.; Lentendu, G.; Wubet, T.; Buscot, F.; Reitz, T. Mineral vs. organic amendments: Microbial community structure, activity and abundance of agriculturally relevant microbes are driven by long-term fertilization strategies. Front. Microb. 2016, 7, 1446. [Google Scholar] [CrossRef]
- Wu, L.; Jiang, Y.; Zhao, F.; He, X.; Liu, H.; Yu, K. Increased organic fertilizer application and reduced chemical fertilizer application affect the soil properties and bacterial communities of grape rhizosphere soil. Nat. Sci. Rep. 2020, 10, 9568. [Google Scholar] [CrossRef]
- Sivojiene, D.; Kacergius, A.; Baksiene, E.; Maseviciene, A.; Zickiene, L. The influence of organic fertilizers on the abundance of soil microorganism communities, agrochemical indicators, and yield in East Lithuanian light soils. Plants 2021, 10, 2648. [Google Scholar] [CrossRef]
- Morugán-Coronado, A.; García-Orenes, F.; McMillan, M.; Pereg, L. The effect of moisture on soil microbial properties and nitrogen cyclers in Mediterranean sweet orange orchards under organic and inorganic fertilization. Sci. Total Environ. 2019, 655, 158–167. [Google Scholar] [CrossRef]
- Cheng, H.; Yuan, M.; Duan, Q.; Sun, R.; Shen, Y.; Yu, Q. Influence of phosphorus fertilization patterns on the bacterial community in upland farmland. Ind. Crops Prod. 2020, 155, 112. [Google Scholar] [CrossRef]
- Trivedi, P.; Delgado-Baquerizo, M.; Anderson, I.C.; Singh, B.K. Response of soil properties and microbial communities to agriculture: Implications for primary productivity and soil health indicators. Front. Plant Sci. 2016, 7, 990. [Google Scholar] [CrossRef] [PubMed]
- Urra, J.; Alkorta, I.; Garbisu, C. Potential benefits and risks for soil health derived from the use of organic amendments in agriculture. Agronomy 2019, 9, 542. [Google Scholar] [CrossRef]
- Roussos, P.A.; Gasparatos, D.; Kechrologoua, K.; Katsenos, P.; Bouchagier, P. Impact of organic fertilization on soil properties, plant physiology and yield in two newly planted olive (Olea europaea L.) cultivars under Mediterranean conditions. Sci. Hort. 2017, 220, 11–19. [Google Scholar] [CrossRef]
- Hua, K.; Zhu, B. Phosphorus loss through surface runoff and leaching in response to the long-term application of different organic amendments on sloping croplands. J. Soils Sed. 2020, 20, 3459–3471. [Google Scholar] [CrossRef]
- Triberti, L.; Nastri, A.; Baldoni, G. Long-term effects of crop rotation, manure and mineral fertilization on carbon sequestration and soil fertility. Eur. J. Agron. 2016, 74, 47–55. [Google Scholar] [CrossRef]
- Martín-Lammerding, D.; Gabriel, J.L.; Zambrana, E.; Santín-Montanyá, I.; Tenorio, J.L. Organic amendment vs. mineral fertilization under minimum tillage: Changes in soil nutrients, soil organic matter, biological properties and yield after 10 years. Agriculture 2021, 11, 700. [Google Scholar] [CrossRef]
- Liu, X.; Zhang, Y.; Wang, F. Effect of reduced subsequent N supply and organic amendment on soil bacterial community in a wheat-maize rotation system with over-fertilization. Appl. Soil Ecol. 2023, 181, 104659. [Google Scholar] [CrossRef]
- Yang, T.; Siddique, K.H.M.; Liu, K. Cropping systems in agriculture and their impact on soil health—A review. Glob. Ecol. Cons. 2020, 23, e01118. [Google Scholar] [CrossRef]
- Dhakal, D.; Islam, M.A. Grass-Legume mixtures for improved soil health in cultivated agroecosystem. Sustainability 2018, 10, 2718. [Google Scholar] [CrossRef]
- Fox, A.; Lüscher, A.; Widmer, F. Plant species identity drives soil microbial community structures that persist under a following crop. Ecol. Evol. 2020, 10, 8652–8668. [Google Scholar] [CrossRef]
- Stefan, L.; Hartmann, M.; Engbersen, N.; Six, J.; Schöb, C. Positive effects of crop diversity on productivity driven by changes in soil microbial composition. Front. Microb. 2021, 12, 660749. [Google Scholar] [CrossRef]
- Turner, T.R.; Ramakrishnan, K.; Walshaw, J.; Heavens, D.; Alston, M.; Swarbreck, D.; Osbourn, A.; Grant, A.; Poole, P.S. Comparative meta-transcriptomics reveals kingdom level changes in the rhizosphere microbiome of plants. ISME J. 2013, 7, 2248–2258. [Google Scholar] [CrossRef]
- Wen, Z.; Yao, W.; Han, M.; Xu, X.; Wu, F.; Yang, M.; Fazal, A.; Yin, T.; Qi, J.; Lu, G.; et al. Differential assembly of root-associated bacterial and fungal communities of a dual transgenic insect-resistant maize line at different host niches and different growth stages. Front. Microb. 2022, 13, 1023971. [Google Scholar] [CrossRef]
- Hayes, R.C.; Gupta, V.V.S.R.; Li, G.D.; Peoples, M.B.; Rawnsley, R.P.; Pembleton, K.G. Contrasting soil microbial abundance and diversity on and between pasture drill rows in the third growing season after sowing. Renew. Agric. Food Syst. 2021, 36, 163–172. [Google Scholar] [CrossRef]
- Waring, B.G.; Álvarez-Cansino, L.; Barry, K.E.; Becklund, K.K.; Dale, S.; Gei, M.G.; Keller, A.B.; Lopez, O.R.; Markesteijn, L.; Mangan, S.; et al. Pervasive and strong effects of plants on soil chemistry: A meta-analysis of individual plant ‘Zinke’ effects. Proc. R. Soc. B 2015, 282, 20151001. [Google Scholar] [CrossRef]
- Kwiatkowski, C.A.; Harasim, E. Chemical properties of soil in four-field crop rotations under organic and conventional farming systems. Agronomy 2020, 10, 1045. [Google Scholar] [CrossRef]
- Stagnari, F.; Maggio, A.; Galieni, A.; Pisante, M. Multiple benefits of legumes for agriculture sustainability: An overview. Chem. Biol. Technol. Agric. 2017, 4, 2. [Google Scholar] [CrossRef]
- Wozniak, A. Chemical properties and enzyme activity of soil as affected by tillage system and previous crop. Agriculture 2019, 9, 262. [Google Scholar] [CrossRef]
- Satellites.Pro. Available online: https://satellites.pro/Moara_Domneasca_map.Ilfov.Romania# (accessed on 25 August 2023).
- Blaga, G.; Paulette, L.; Udrescu, S.; Filipov, F.; Rusu, I.; Dumitru, V. Pedology; Mega: Cluj-Napoca, Romania, 2008; pp. 346–350. ISBN 978-973-1868-26-4. (In Romanian) [Google Scholar]
- STAS 7184/3-77; Soils. Determination of Density and Bulk Density. ASRO: Bucharest, Romania, 2019. (In Romanian)
- STAS 7184/5-78; Soils. Determination of Total Porosity and Aeration Porosity. ASRO: Bucharest, Romania, 2019. (In Romanian)
- Mihalache, M.; Ilie, L. Pedology-Romania’s Soils; Dominor: Bucharest, Romania, 2008; ISBN 978-973-1838-71-7. (In Romanian) [Google Scholar]
- SR 7184-13:2001; Soils. Determination of pH in Aqueous and Saline Suspensions (Mass/Volume) and in Saturated Paste. Romanian Standards Association: Bucharest, Romania, 2001. (In Romanian)
- Walkley, A.; Black, I.A. An examination of the Degtjareff method for determining soil organic matter, and a proposed modification of the chromic acid titration method. Soil Sci. 1934, 37, 29–38. [Google Scholar] [CrossRef]
- De Oliveira, E. Sample preparation for atomic spectroscopy: Evolution and future trends. J. Braz. Chem. Soc. 2003, 14, 174–182. [Google Scholar] [CrossRef]
- STAS 7184/19-82; Soils. Determination of Phosphorus. ASRO: Bucharest, Romania, 1982. (In Romanian)
- STAS 7184/2-85; Soils. Determination of Nitrogen Content. ASRO: Bucharest, Romania, 1985. (In Romanian)
- Lăcătușu, R.; Lungu, M.; Rizea, N. Soil Global Chemistry—Processes, Determinations, Interpretation; Terra Nostra: Iași, Romania, 2017; ISBN 978-606-623-074-2. (In Romanian) [Google Scholar]
- Desay, C.; Parikh, R.Y.; Vaishnav, T.; Shouche, Y.S.; Madamwar, D. Tracking the influence of long-term chromium pollution on soil bacterial community structures by comparative analyses of 16S rRNA gene phylotypes. Res. Microb. 2009, 160, 1–9. [Google Scholar] [CrossRef]
- Corry, J.E.L.; Curtis, G.D.W.; Baird, R.M. Rose Bengal Chloramphenicol (RBC) Agar. In Progress in Industrial Microbiology; Elsevier: Amsterdam, The Netherlands, 2003; Volume 37, pp. 586–588. ISBN 9780444814982. [Google Scholar]
- Johnsen, K.; Nielsen, P. Diversity of Pseudomonas strains isolated with King’s B and Gould’s S1 agar determined by repetitive extragenic palindromic-polymerase chain reaction, 16S rDNA sequencing and Fourier transform infrared spectroscopy characterisation. FEMS Microb. Lett. 1999, 173, 155–162. [Google Scholar] [CrossRef]
- Dobre, A.; Marin, L.A.; Manole, C.; Andrei, N.; Cornea, C.P. Evaluation of the capacity of different microorganisms to solubilize several compounds of phosphorous and zinc. Sci. Bull. Ser. F. Biotech. 2016, XX, 254–262. [Google Scholar]
- Agrawal, T.; Kotasthane, A.S. Chitinolytic assay of indigenous Trichoderma isolates collected from different geographical locations of Chhattisgarh in Central India. SpringerPlus 2012, 1, 73. [Google Scholar] [CrossRef] [PubMed]
- Sicuia, O.A.; Grosu, I.; Constantinescu, F.; Voaideş, C.; Cornea, P.C. Enzymatic and genetic variability in Bacillus spp. strains with plant-beneficial qualities. AgroLife Sci. J. 2015, IV, 124–131. [Google Scholar] [CrossRef]
- Boiu-Sicuia, O.A.; Toma, R.C.; Diguță, F.C.; Matei, F.; Cornea, C.P. In vitro evaluation of some endophytic Bacillus to potentially inhibit grapes and grapevine fungal pathogens. Plants 2023, 12, 2553. [Google Scholar] [CrossRef] [PubMed]
- Hahn, N.J. The Congo red reaction in bacteria and its usefulness in the identification of rhizobia. Can. J. Microb. 1966, 12, 725–733. [Google Scholar] [CrossRef]
- Soares, R.; Trejo, J.; Lorite, M.J.; Figueira, E.; Sanjuán, J.; Videira e Castro, I. Diversity, phylogeny and plant growth promotion traits of nodule associated bacteria isolated from Lotus parviflorus. Microorganisms 2020, 8, 499. [Google Scholar] [CrossRef]
- Somasegaran, P.; Hoben, H.J. Handbook for Rhizobia: Methods in Legume-Rhizobium Technology; Springer: Berlin, Germany, 1994; ISBN 0-387-94134-7. [Google Scholar]
- Boiu-Sicuia, O.A.; Stan, V.; Cornea, C.P. The compost, a source of plant beneficial bacteria with biocontrol potential. Curr. Trends Nat. Sci. 2021, 10, 32–38. [Google Scholar] [CrossRef]
- EN ISO 10390:2022; Soil, Treated Biowaste and Sludge—Determination of pH. European Commission: Brussels, Belgium, 2022. Available online: https://standards.iteh.ai/catalog/standards/cen/35c1e689-fbc3-4bd2-a9e7-7162f61ae30b/en-iso-10390-2022 (accessed on 18 October 2023).
- Compact Dry—An Easy Test Method for Counting Microorganisms. Available online: https://www.laensenadacorp.com/documentos/r-biopharm-COMPACT-DRY.pdf (accessed on 18 October 2023).
- EN ISO 6579-1:2017; Microbiology of the Food Chain—Horizontal Method for the Detection, Enumeration and Serotyping of Salmonella-Part1: Detection of Salmonella spp. ISO: Geneva, Switzerland, 2017. Available online: https://cdn.standards.iteh.ai/samples/76671/2e4fa9e44397450c83ba47e356c3dfe5/ISO-6579-1-2017-Amd-1-2020.pdf (accessed on 21 October 2023).
- Fernández, R.M.; Gómez, J.M.; Estrada, I.B. Compost legislation: Sanitization vs. Biological Quality. In Proceedings of the I International Conference Soil and Compost Eco-Biology, León, Spain, 15–17 September 2004. [Google Scholar]
- Canadian Council of Ministers of the Environment (CCME). Guidelines for Compost Quality; CCME: Winnipeg, MB, Canada, 2005; pp. 1–26. [Google Scholar]
- Blaga, G.; Rusu, I.; Udrescu, S.; Vasile, D. Pedology; Academic Press: Bucharest, Romania, 2005; ISBN 973-744-004-8. (In Romanian) [Google Scholar]
- Tesfahunegn, G.B.; Tamen, L.; Vlek, P.L.G. Evaluation of soil quality identified by local farmers in Mai-Negus catchment, northern Ethiopia. Geoderma 2011, 163, 209–218. [Google Scholar] [CrossRef]
- Zhang, J.J.; Gao, H.J.; Zhu, P.; Gao, Q.; Wang, L.C. Effects of long-term fertilization and cropping regimes on total nitrogen and organic nitrogen forms in a Mollisol of Northeast China. Plant Soil Environ. 2014, 60, 544–549. [Google Scholar] [CrossRef]
- Liu, Z.; Rong, Q.; Zhou, W.; Liang, G. Effects of inorganic and organic amendment on soil chemical properties, enzyme activities, microbial community and soil quality in yellow clayey soil. PLoS ONE 2017, 12, e0172767. [Google Scholar] [CrossRef]
- Deru, J.G.C.; Bloem, J.; de Goede, R.; Brussaard, L.; van Eekeren, N. Effects of organic and inorganic fertilizers on soil properties related to the regeneration of ecosystem services in peat grasslands. Appl. Soil Ecol. 2023, 187, 104838. [Google Scholar] [CrossRef]
- Zeng, M.; De Vries, W.; Bonten, L.T.C.; Zhu, Q.; Hao, T.; Liu, X.; Xu, M.; Shi, X.; Zhang, F.; Shen, J. Model-Based Analysis of the Long-Term Effects of Fertilization Management on Cropland Soil Acidification. Environ. Sci. Technol. 2017, 51, 3843–3851. [Google Scholar] [CrossRef]
- Lemaire, G.; Tang, L.; Bélanger, G.; Zhu, Y.; Jeuffroy, M.H. Forward new paradigms for crop mineral nutrition and fertilization towards sustainable agriculture. Eur. J. Agron. 2021, 125, 126248. [Google Scholar] [CrossRef]
- Kumar, V.; Ghosh, B.C.; Bhat, R. Complementary effect of crop wastes and inorganic fertilizers on yield, nutrient uptake and residual fertility in mustard (Brassica juncea)-rice (Oryza sativa) cropping sequence. Ind. J. Agric. Sci. 2000, 70, 69–72. [Google Scholar]
- Rocci, K.S.; Lavallee, J.M.; Stewart, C.E.; Cotrufo, M.F. Soil organic carbon response to global environmental change depends on its distribution between mineral-associated and particulate organic matter: A meta-analysis. Sci. Total Environ. 2021, 793, 148569. [Google Scholar] [CrossRef] [PubMed]
- Mi, W.; Sun, Y.; Gao, Q.; Liu, M.; Wu, L. Changes in humus carbon fractions in paddy soil given different organic amendments and mineral fertilizers. Soil Till. Res. 2019, 195, 104421. [Google Scholar] [CrossRef]
- Angelova, V.R.; Akova, V.I.; Artinova, N.S.; Ivanov, K.I. The effect of organic amendments on soil chemical characteristics. Bulg. J. Agric. Sci. 2013, 19, 958–971. [Google Scholar]
- Li, S.; Li, J.; Li, G.; Li, Y.; Yuan, J.; Li, D. Effect of different organic fertilizers application on soil organic matter properties. Comp. Sci. Utiliz. 2017, 25, 31–36. [Google Scholar] [CrossRef]
- Rosa, E.; Debska, B. Seasonal changes in the content of dissolved organic matter in arable soils. J. Soils Sediments 2018, 18, 2703–2714. [Google Scholar] [CrossRef]
- Deng, L.; Peng, C.; Kim, D.L.; Li, J.; Liu, Y.; Hai, X.; Liu, Q.; Huang, C.; Shangguan, Z.; Kuzyakov, Y. Drought effects on soil carbon and nitrogen dynamics in global natural ecosystems. Earth-Sci. Rev. 2021, 214, 103501. [Google Scholar] [CrossRef]
- Taylor, A.A.; De-Felice, J.; Havill, D.C. Seasonal variation in nitrogen availability and utilization in an acidic and calcareous soil. New Phytol. 1982, 92, 141–152. [Google Scholar] [CrossRef]
- Kravchenko, Y.; Yarosh, A.; Chen, Y. Profile Soil Carbon and Nitrogen Dynamics in Typical Chernozem under Long-Term Tillage Use. Land 2022, 11, 1165. [Google Scholar] [CrossRef]
- Paz-Ferreiro, J.; Mendez, A.; Gascó, G.; Guo, M.; He, Z.; Uchimya, S.M. Application of Biochar for Soil Biological Improvement. In Agricultural and Environmental Applications of Biochar: Advances and Barriers; Guo, M., He, Z., Uchimiya, S.M., Eds.; Soil Science Society of America, Inc.: Madison, WI, USA, 2016. [Google Scholar]
- He, J.; He, Y.; Gao, W.; Chen, Y.; Ma, G.; Ji, R.; Liu, X. Soil depth and agricultural irrigation activities drive variation in microbial abundance and nitrogen cycling. Catena 2022, 219, 106596. [Google Scholar] [CrossRef]
- Ma, W.; Yang, Z.; Liang, L.; Ma, Q.; Wang, G.; Zhao, T. Seasonal changes in soil microbial community and co-occurrence network of species of the genus Corylus. Microorganisms 2021, 9, 2228. [Google Scholar] [CrossRef]
- Verdenelli, R.A.; Dominchin, M.F.; Pérez-Brandan, C.; Rovea, A.; Vargas-Gil, S.; Meriles, J.M. Effect of long-term mineral fertilization on soil microbial abundance, community structure and diversity in a Typic Hapludoll under intensive farming systems. Ann. Appl. Biol. 2019, 175, 363–375. [Google Scholar] [CrossRef]
- Geisseler, D.; Scow, K.M. Long-term effects of mineral fertilizers on soil microorganisms- A review. Soil Biol. Biochem. 2014, 75, 54–63. [Google Scholar] [CrossRef]
- Lazcano, C.; Gómez-Brandón, M.; Revilla, P.; Domínguez, J. Short-term effects of organic and inorganic fertilizers on soil microbial community structure and function. Biol. Fertil. Soils 2013, 49, 723–733. [Google Scholar] [CrossRef]
- Helepciuc, F.E.; Mitoi, E.M.; Brezeanu, A.; Cornea, C.P. Root colonization capacity by plant beneficial bacteria. AgroLife Sci. J. 2019, 8, 48–53. [Google Scholar]
- Yu, K.; van den Hoogen, J.; Wang, Z.; Averill, C.; Routh, D.; Smith, G.R.; Drenovsky, R.E.; Scow, K.M.; Mo, F.; Waldrop, M.P.; et al. The biogeography of relative abundance of soil fungi versus bacteria in surface topsoil. Earth Syst. Sci. Data 2022, 14, 4339–4350. [Google Scholar] [CrossRef]
- Ling, N.; Chen, D.; Guo, H.; Wei, J.; Bai, Y.; Shen, Q.; Hu, S. Differential responses of soil bacterial communities to long-term N and P inputs in a semi-arid steppe. Geoderma 2017, 292, 25–33. [Google Scholar] [CrossRef]
- Liu, Z.; Xie, W.; Yang, Z.; Huang, X.; Zhou, H. Effects of manure and chemical fertilizer on bacterial community structure and soil enzyme activities in North China. Agronomy 2021, 11, 1017. [Google Scholar] [CrossRef]
- Calderon, R.B.; Jeong, C.; Ku, H.-H.; Coghill, L.M.; Ju, Y.J.; Kim, N.; Ham, J.H. Changes in the microbial community in soybean plots treated with biochar and poultry litter. Agronomy 2021, 11, 1428. [Google Scholar] [CrossRef]
- Lourenço, K.S.; Suleiman, A.K.A.; Pijl, A.; Cantarella, H.; Kuramae, E.E. Dynamics and resilience of soil mycobiome under multiple organic and inorganic pulse disturbances. Sci. Total Environ. 2020, 733, 139173. [Google Scholar] [CrossRef] [PubMed]
- Enebe, M.C.; Babalola, O.O. Effects of inorganic and organic treatments on the microbial community of maize rhizosphere by a shotgun metagenomics approach. Ann. Microb. 2020, 70, 49. [Google Scholar] [CrossRef]
- Guo, Z.; Wan, S.; Hua, K.; Yin, Y.; Chu, H.Y.; Wang, D.; Guo, X. Fertilization regime has a greater effect on soil microbial community structure than crop rotation and growth stage in an agroecosystem. Appl. Soil Ecol. 2020, 149, 103510. [Google Scholar] [CrossRef]
- Ai, C.; Zhang, S.; Zhang, X.; Guo, D.; Zhou, W.; Huang, S. Distinct responses of soil bacterial and fungal communities to changes in fertilization regime and crop rotation. Geoderma 2018, 319, 156–166. [Google Scholar] [CrossRef]
- Liang, R.; Hou, R.; Li, J.; Lyu, Y.; Hang, S.; Gong, H.; Ouyang, Z. Effects of different fertilizers on rhizosphere bacterial communities of winter wheat in the North China Plain. Agronomy 2020, 10, 93. [Google Scholar] [CrossRef]
- Petatán-Sagahón, I.; Anducho-Reyes, M.A.; Silva-Rojas, H.V.; Arana-Cuenca, A.; Tellez-Jurado, A.; Cárdenas-Álvarez, I.O.; Mercado-Flores, Y. Isolation of bacteria with antifungal activity against the phytopathogenic fungi Stenocarpella maydis and Stenocarpella macrospora. Int. J. Mol. Sci. 2011, 12, 5522–5537. [Google Scholar] [CrossRef]
- Semenov, M.V.; Krasnov, G.S.; Semenov, V.M.; van Bruggen, A. Mineral and Organic Fertilizers Distinctly Affect Fungal Communities in the Crop Rhizosphere. J. Fungi 2022, 8, 251. [Google Scholar] [CrossRef]
- Zhao, X.; Hou, D.; Xu, J.; Wang, K.; Hu, Z. Antagonistic Activity of Fungal Strains against Fusarium Crown Rot. Plants 2022, 11, 255. [Google Scholar] [CrossRef] [PubMed]
- Shahane, A.A.; Shivay, Y.S. Soil health and its improvement through novel agronomic and innovative approaches. Front. Agron. 2021, 3, 680456. [Google Scholar] [CrossRef]
- Dincă, L.C.; Grenni, P.; Onet, C.; Onet, A. Fertilization and Soil Microbial Community: A Review. Appl. Sci. 2022, 12, 1198. [Google Scholar] [CrossRef]

| Treatment | Mixture of Perennial Grasses and Legumes | Winter Wheat | Maize | Soybean | ||||||
|---|---|---|---|---|---|---|---|---|---|---|
| Doses of Fertilizers | ||||||||||
| Fraction (kg/ha) | Fraction (kg/ha) | Fraction (kg/ha) | Fraction (kg/ha) | |||||||
| 1 | 2 | 1 | 2 | 1 | 2 | 3 | 1 | 2 | 3 | |
| BBCH stages for different fertilizer dose applications * | ||||||||||
| 22 | 29 | 27 | 31 | 00 | 13 | 16 | 00 | 12 | 19 | |
| V1—soil (Control) | - | - | - | - | - | - | - | - | - | - |
| V2—NPK | 40 N; 40 P2O5; 0 K2O | 40 N; 40 P2O5; 0 K2O | 57 N; 57 P2O5; 0 K2O | 40 N;40 P2O5; 0 K2O | 28 N; 28 P2O5 0 K2O | 46 N; 46 P2O5; 0 K2O | 29 N; 29 P2O5; 0 K2O | 18 N; 18 P2O5 0 K2O | 20 N; 20 P2O5; 0 K2O | 13 N; 13 P2O5; 0 K2O |
| V3—15 t/ha MC | - | - | - | - | - | - | - | - | - | - |
| V4—15 t/ha MC + NPK | 29 N; 29 P2O5; 0 K2O | 29 N; 29 P2O5; 0 K2O | 42 N; 42 P2O5; 0 K2O | 21 N; 21 P2O5; 0 K2O | 29 N; 29 P2O5 0 K2O | 34 N; 34 P2O5; 0 K2O | 21 N; 21 P2O5; 0 K2O | 16 N; 16 P2O5; 0 K2O | 18 N; 18 P2O5; 0 K2O | 11 N; 11 P2O5 0 K2O |
| V5—30 t/ha MC | - | - | - | - | - | - | - | - | - | - |
| V6—30 t/ha MC + NPK | 18 N; 18 P2O5; 0 K2O | 18N; 18 P2O5; 0 K2O | 27 N; 27P2O5; 0 K2O | 13 N; 13 P2O5; 0 K2O | 19 N; 19P2O5; 0 K2O | 22 N; 22 P2O5; 0 K2O | 14 N;14 P2O5; 0 K2O | 13 N;13 P2O5; 0 K2O | 15 N 15 P2O5; 0 K2O | 9 N; 9 P2O5; 0 K2O |
| V7—60 t/ha MC | - | - | - | - | - | - | - | - | - | - |
| V8—60 t/ha MC + NPK | According to dose calculation, in V8, for the mixture of perennial grasses and legumes, winter wheat, and maize, the amount of MC should have ensured the nutrient requirements (NPK) and it was decided not to supplement it with chemical fertilizers | 8 N; 8 P2O5; 0 K2O | 10 N 10 P2O5 0 K2O | 6 N; 6 P2O5; 0 K2O | ||||||
| Manure Compost Chemical Properties | Measurement Unit | Mean Value ± SD |
|---|---|---|
| pH | - | 8.00 ± 0.097 |
| Corg | % | 21.58 ± 0.359 |
| Nt | % | 1.76 ± 0.030 |
| C: N Ratio | - | 12.26 ± 0.190 |
| N-NO3 | mg/kg d.m. | 431.5 ± 206.7 |
| N-NH4 | mg/kg d.m. | 763.5 ± 158.5 |
| Pt | % | 0.603 ± 0.019 |
| Kt | % | 2.575 ± 0.148 |
| Microbial Composition | Measurement Unit | Average Microbial Load |
|---|---|---|
| Enterobacteriaceae | CFU/mL | 11 × 103 |
| Escherichia coli and coliforms | CFU/mL | 8.37 × 103 |
| Salmonella | CFU/mL | nd |
| Cultivable bacteria | CFU/g soil | 4.25 × 108 |
| Fungi | CFU/g soil | 9.14 × 104 |
| Fluorescent Pseudomonads | CFU/g soil | 3.53 × 107 |
| Microorganisms that solubilize inorganic phosphorus | CFU/g soil | 2.12 × 107 |
| Cellulolytic microorganisms | CFU/g soil | 6.22 × 107 |
| Proteolytic microorganisms | CFU/g soil | 4.18 × 107 |
| Phytopathogenic Fungus | Measurement Unit | Antifungal Efficacy (E) (Mean Values) |
|---|---|---|
| Fusarium graminearum | % | 79.98 ± 6.89 |
| Fusarium culmorum | % | 83.32 ± 9.36 |
| Sclerotium bataticola | % | 79.76 ± 4.46 |
| Sclerotinia sclerotiorum | % | 73.58 ± 4.02 |
| Soil Chemical Properties | Measurement Unit | Value ± SD |
|---|---|---|
| pH | - | 5.89 ± 0.176 |
| Corg | % | 1.94 ± 0.113 |
| Humus | % | 3.34 ± 0.196 |
| Nt | % | 0.20 ± 0.012 |
| N-NO3 | mg/kg d.m. | 11.85 ± 4.80 |
| N-NH4 | mg/kg d.m. | 12.14 ± 3.60 |
| Available P | mg/kg d.m | 65.50 ± 13.60 |
| Available K | mg/kg d.m | 231.70 ± 30.20 |
| Soil Chemical Properties | Measurement Unit | Mean Values ± SD |
|---|---|---|
| pH | - | 5.89 ± 0.148 |
| Corg | % | 2.11 ± 0.078 |
| Humus | % | 3.65 ± 0.135 |
| Nt | % | 0.17 ± 0.006 |
| Microbial Composition | Measurement Unit | Average Microbial Load |
|---|---|---|
| Cultivable bacteria | CFU/g soil | 3.7 × 107 |
| Fungi | CFU/g soil | 2.0 × 105 |
| Fluorescent pseudomonads | CFU/g soil | 6.5 × 106 |
| Microorganisms that solubilize inorganic phosphorus | CFU/g soil | 4.0 × 106 |
| Chitinolytic microorganisms | CFU/g soil | 7.5 × 106 |
| Cellulolytic microorganisms | CFU/g soil | 4.5 × 106 |
| Proteolytic microorganisms | CFU/g soil | 8.0 × 106 |
| Rhizobia | CFU/g soil | 1.3 × 106 |
| Microbial Composition | V1—Control | V2—NPK | V3—15 t/ha MC | V4—15 t/ha MC + NPK | V5—30 t/ha MC | V6—30 t/ha MC + NPK | V7—60 t/ha MC | V8—60 t/ha MC + NPK |
|---|---|---|---|---|---|---|---|---|
| Mixture of perennial grasses and legumes experiment | ||||||||
| Fungi (CFU/g) | 4.9 × 105 | 3.5 × 105 | 5.3 × 105 | 7.4 × 105 | 3.4 × 105 | 4.2 × 105 | 1.8 × 105 | 5.1 × 105 |
| Cultivable bacteria (CFU/g) | 4.0 × 107 | 4.5 × 107 | 7.5 × 107 | 4.0 × 107 | 5.0 × 107 | 5.5 × 107 | 2.0 × 107 | 4.5 × 107 |
| Fluorescent pseudomonads (CFU/g) | ≤103 | ≤103 | ≤103 | ≤103 | ≤103 | ≤103 | ≤103 | ≤103 |
| Microorganisms that solubilize inorganic phosphorus (CFU/g) | 3.5 × 106 | 3.5 × 106 | 5.5 × 106 | 7.5 × 106 | 4.5 × 106 | 5.0 × 106 | 3.0 × 106 | 5.5 × 106 |
| Chitinolytic microorganisms (CFU/g) | 2.5 × 106 | 9.5 × 106 | 8.5 × 106 | 4.0 × 106 | 3.0 × 106 | 4.5 × 106 | 3.0 × 106 | 5.5 × 106 |
| Cellulolytic microorganisms (CFU/g) | 1.8 × 107 | 2.4 × 107 | 1.6 × 107 | 2.3 × 107 | 1.0 × 107 | 1.6 × 107 | 1.0 × 107 | 1.0 × 106 |
| Proteolytic microorganisms (CFU/g) | 8.0 × 106 | 3.0 × 107 | 1.6 × 107 | 1.0 × 107 | 1.0 × 107 | 1.5 × 107 | 7.0 × 106 | 1.2 × 107 |
| Rhizobia (CFU/g soil) | 3.1 × 106 | 2.8 × 106 | 3.9 × 106 | 3.7 × 106 | 1.6 × 106 | 2.0 × 106 | 2.2 × 106 | 3.9 × 106 |
| Winter wheat experiment | ||||||||
| Fungi (CFU/g) | 2.2 × 105 | 1.1 × 105 | 1.6 × 105 | 1.4 × 105 | 2.9 × 105 | 1.9 × 105 | 1.6 × 105 | 2.4 × 105 |
| Cultivable bacteria (CFU/g) | 3.5 × 107 | 3.0 × 107 | 1.0 × 107 | 4.0 × 107 | 4.0 × 107 | 5.5 × 107 | 2.5 × 107 | 1.5 × 107 |
| Fluorescent pseudomonades (CFU/g) | 1 × 103 | ≤103 | 1 × 103 | ≤103 | 1 × 103 | ≤103 | 1 × 103 | ≤103 |
| Microorganisms that solubilize inorganic phosphorus (CFU/g) | 9.5 × 105 | 1.5 × 106 | 9.0 × 105 | 1.0 × 106 | 3.5 × 106 | 8.0 × 106 | 2.0 × 106 | 1.0 × 106 |
| Chitinolytic microorganisms (CFU/g) | 8.3 × 105 | 2.0 × 105 | 6.0 × 105 | 1.0 × 105 | 9.5 × 105 | 9.5 × 105 | 1.0 × 106 | 1.0 × 106 |
| Cellulolytic microorganisms (CFU/g) | 6.5 × 106 | 5.0 × 106 | 6.5 × 106 | 6.0 × 106 | 7.0 × 106 | 9.5 × 106 | 8.0 × 106 | 7.5 × 106 |
| Proteolytic microorganisms (CFU/g) | 1.0 × 106 | 7.0 × 106 | 2.0 × 106 | <106 | 6.0 × 106 | 1.1 × 106 | 7.5 × 106 | 4.0 × 106 |
| Rhizobia (CFU/g soil) | 3.6 × 106 | 3.4 × 106 | 2.3 × 106 | 3.4 × 106 | 2.9 × 106 | 4.0 × 106 | 3.6 × 106 | 2.7 × 106 |
| Soybean experiment | ||||||||
| Fungi (CFU/g) | 2.9 × 105 | 2.1 × 105 | 0.9 × 105 | 0.8 × 105 | 0.8 × 105 | 0.7 × 105 | 0.9 × 105 | 0.9 × 105 |
| Cultivable bacteria (CFU/g) | 2.5 × 107 | 2.0 × 107 | 2.0 × 107 | 1.5 × 107 | 3.0 × 107 | 3.0 × 107 | 3.5 × 107 | 2.5 × 107 |
| Fluorescent pseudomonades (CFU/g) | 1 × 103 | ≤103 | 1 × 104 | ≤104 | ≤104 | ≤103 | ≤104 | ≤103 |
| Microorganisms that solubilize inorganic phosphorus (CFU/g) | 2.5 × 106 | 1.5 × 106 | 1.0 × 106 | 0.3 × 106 | 1.0 × 106 | 0.5 × 106 | 1.0 × 106 | 1.0 × 106 |
| Chitinolytic microorganisms (CFU/g) | 5.0 × 105 | 1.3 × 106 | 1.0 × 106 | 5.0 × 105 | 3.0 × 105 | 1.0 × 106 | 6.0 × 105 | 1.0 × 106 |
| Cellulolytic microorganisms (CFU/g) | 6.0 × 106 | 5.5 × 106 | 5.5 × 106 | 4.0 × 106 | 4.5 × 106 | 6.5 × 106 | 4.5 × 106 | 2.0 × 106 |
| Proteolytic microorganisms (CFU/g) | 9.0 × 106 | 5.0 × 106 | 9.5 × 106 | 2.0 × 106 | 6.0 × 106 | 6.5 × 106 | 4.0 × 106 | 1.0 × 106 |
| Rhizobia (CFU/g soil) | 4.6 × 106 | 2.7 × 106 | 2.6 × 106 | 1.6 × 106 | 3.8 × 106 | 1.5 × 106 | 1.2 × 106 | 2.8 × 106 |
| Maize experiment | ||||||||
| Fungi (CFU/g) | 4.6 × 105 | 3.1 × 105 | 3.3 × 105 | 5.2 × 105 | 3.8 × 105 | 4.4 × 105 | 4.7 × 105 | 4.2 × 105 |
| Cultivable bacteria (CFU/g) | 6.0 × 107 | 4.5 × 107 | 3.0 × 107 | 3.5 × 107 | 7.0 × 107 | 3.5 × 107 | 7.0 × 107 | 4.5 × 107 |
| Fluorescent pseudomonads (CFU/g) | ≤103 | ≤103 | ≤103 | ≤103 | ≤103 | ≤103 | ≤103 | ≤103 |
| Microorganisms that solubilize inorganic phosphorus (CFU/g) | 5.0 × 106 | 3.5 × 106 | 4.5 × 106 | 4.0 × 106 | 7.0 × 106 | 5.0 × 106 | 6.0 × 106 | 4.0 × 106 |
| Chitinolytic microorganisms (CFU/g) | 4.0 × 106 | 5.0 × 106 | 4.5 × 106 | 2.5 × 106 | 4.3 × 106 | 4.0 × 106 | 2.5 × 106 | 3.0 × 106 |
| Cellulolytic microorganisms (CFU/g) | 2.0 × 107 | 2.0 × 107 | 2.0 × 107 | 1 × 107 | 1.1 × 107 | 1.3 × 107 | 4.3 × 107 | 1.1 × 107 |
| Proteolytic microorganisms (CFU/g) | 7.0 × 106 | 7.5 × 106 | 7.0 × 106 | 7.5 × 106 | 8.0 × 106 | 1.5 × 107 | 1.5 × 107 | 8.0 × 106 |
| Rhizobia (CFU/g soil) | 2.2 × 106 | 1.5 × 106 | 1.1 × 106 | 2.0 × 106 | 1.4 × 106 | 1.0 × 106 | 2.9 × 106 | 1.1 × 106 |
| Phytopathogenic Fungus | Measurement Unit | Antifungal Efficacy of Microorganisms (E) (Mean Values) |
|---|---|---|
| Fusarium graminearum | % | 82.22 ± 9.55 |
| Fusarium culmorum | % | 80.12 ± 9.28 |
| Sclerotium bataticola | % | 80.50 ± 6.35 |
| Sclerotinia sclerotiorum | % | 73.95 ± 4.99 |
Disclaimer/Publisher’s Note: The statements, opinions and data contained in all publications are solely those of the individual author(s) and contributor(s) and not of MDPI and/or the editor(s). MDPI and/or the editor(s) disclaim responsibility for any injury to people or property resulting from any ideas, methods, instructions or products referred to in the content. |
© 2023 by the authors. Licensee MDPI, Basel, Switzerland. This article is an open access article distributed under the terms and conditions of the Creative Commons Attribution (CC BY) license (https://creativecommons.org/licenses/by/4.0/).
Share and Cite
Dușa, E.M.; Stan, V.; Vrînceanu, N.; Mihalache, M.; Vasile, M.; Sicuia, O.; Voaideș, C. Soil Chemical Properties and Microbial Behavior under Short-Term Organic and Mineral Fertilization within Different Crops. Agronomy 2023, 13, 2837. https://doi.org/10.3390/agronomy13112837
Dușa EM, Stan V, Vrînceanu N, Mihalache M, Vasile M, Sicuia O, Voaideș C. Soil Chemical Properties and Microbial Behavior under Short-Term Organic and Mineral Fertilization within Different Crops. Agronomy. 2023; 13(11):2837. https://doi.org/10.3390/agronomy13112837
Chicago/Turabian StyleDușa, Elena Mirela, Vasilica Stan, Nicoleta Vrînceanu, Mircea Mihalache, Mihaela Vasile, Oana Sicuia, and Cătălina Voaideș. 2023. "Soil Chemical Properties and Microbial Behavior under Short-Term Organic and Mineral Fertilization within Different Crops" Agronomy 13, no. 11: 2837. https://doi.org/10.3390/agronomy13112837
APA StyleDușa, E. M., Stan, V., Vrînceanu, N., Mihalache, M., Vasile, M., Sicuia, O., & Voaideș, C. (2023). Soil Chemical Properties and Microbial Behavior under Short-Term Organic and Mineral Fertilization within Different Crops. Agronomy, 13(11), 2837. https://doi.org/10.3390/agronomy13112837

